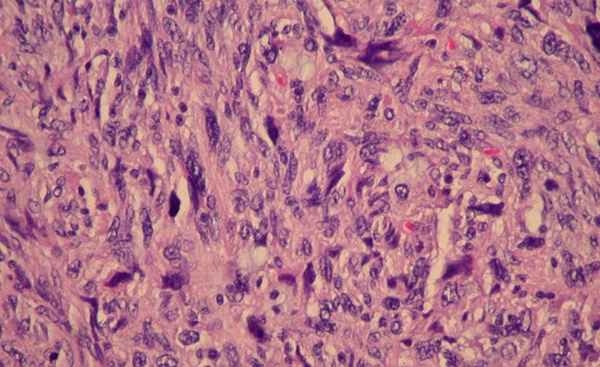
Курсы по патологической анатомии

Пирамида височной кости. Топография височной кости
Добавил пользователь Morpheus Обновлено: 27.01.2026
Кафедра оториноларингологии - хирургии головы и шеи Медицинского института Северо-Кавказской государственной гуманитарно-технологической академии;
Карачаево-Черкесская республиканская клиническая больница, Черкесск, Россия 369000
Карачаево-Черкесская республиканская клиническая больница, Черкесск, Россия, 369000
Гигантская остеома сосцевидного отростка височной кости
Журнал: Вестник оториноларингологии. 2014;(4): 52‑54
Гюсан А.О., Ламкова А.Х. Гигантская остеома сосцевидного отростка височной кости. Вестник оториноларингологии. 2014;(4):52‑54.
Giusan AO, Lamkova AKh. The giant osteoma of the mastoid process of the temporal bone. Vestnik Oto-Rino-Laringologii. 2014;(4):52‑54. (In Russ.).
Кафедра оториноларингологии - хирургии головы и шеи Медицинского института Северо-Кавказской государственной гуманитарно-технологической академии;
Карачаево-Черкесская республиканская клиническая больница, Черкесск, Россия 369000
Кафедра оториноларингологии - хирургии головы и шеи Медицинского института Северо-Кавказской государственной гуманитарно-технологической академии;
Карачаево-Черкесская республиканская клиническая больница, Черкесск, Россия 369000
Карачаево-Черкесская республиканская клиническая больница, Черкесск, Россия, 369000
До настоящего времени остеомы височной кости относят к казуистическим наблюдениям [1]. Рост остеом может наблюдаться в различных областях височной кости. В большинстве случаев описаны остеомы, исходящие из задней стенки наружного слухового прохода [2], реже - из его верхней и передней стенок [3], из внутреннего слухового прохода [4, 5], барабанной полости, чешуи височной кости 6, сосцевидного отростка 12.
Обычно остеома возникает в каменисто-сосцевидной области, исходной точкой бывают либо одна из воздухоносных ячеек, либо корковый слой одной из внутренних полостей височной кости. Если остеома среднего уха возникает в основании сосцевидного отростка, то она может достигать значительных размеров, заполняя почти всю ретроаурикулярную область.
Остеома среднего уха развивается вследствие пролиферации межкостной или периостальной соединительной ткани, которая метаплазирует в губчатую кость, покрытую корковым слоем. Несмотря на то что васкуляризация остеомы незначительна, она в достаточной степени обеспечивает растущую опухоль необходимыми питательными веществами.
Остеома может иметь компактную, губчатую, хрящевую или смешанную структуру. Известны две формы роста остеом: экзофитная, когда опухоль растет в просвет наружного слухового прохода, и эндофитная - при росте опухоли в толщу сосцевидного отростка. Большинство остеом, особенно обычная остеома костей черепа, представляют собой пороки развития. Встречаются во всех возрастных группах, но наиболее часто между 2-м и 3-м десятилетиями жизни. Соотношение лиц женского и мужского пола - 2:1. Замечено, что чаще остеома начинает расти в период полового созревания.
Остеома среднего уха эволюционирует очень медленно (многие годы) и нередко на каком-то этапе развития перестает увеличиваться. Лишь тогда, когда остеома сопровождается теми или иными функциональными расстройствами или является причиной косметического дефекта, она подлежат хирургическому удалению. Объем хирургического вмешательства определяется локализацией опухоли, ее величиной и распространением.
Клинические проявления остеомы зависят от ее размеров и локализации. Нередко остеома височной кости не сопровождается клиническими признаками. Ее обнаруживают случайно при рентгенологическом исследовании черепа. Некоторые больные жалуются на головную боль, вестибулярные расстройства, чувство тяжести в голове.
Диагностика остеомы среднего уха не вызывает затруднений. Для визуализации размеров и топографии опухоли и выяснения состояния полостей среднего уха и пирамиды височной кости показана рентгенография. На рентгенограмме остеома выглядит как добавочное образование костной плотности и структуры с четкими и ровными контурами (без признаков перифокальных изменений).
Остеома среднего уха не отграничена от костной ткани, из которой она происходит, а плавно переходит в нее.
Приводим собственное наблюдение остеомы сосцевидного отростка. Больная У., 1987 г.р., поступила в ЛОР-отделение республиканской больницы с жалобами на наличие опухолевидного образования за левой ушной раковиной. Впервые заметила появление припухлости за левым ухом 15 лет назад, однако за лечебной помощью не обращалась. В последние месяцы опухоль стала быстро увеличиваться. Выяснить какие-либо причины возникновения остеомы не удалось.

При осмотре общее состояние удовлетворительное, внутренние органы без патологических изменений. Анализы крови и мочи в норме. ЛОР-осмотр: нос, глотка, гортань - без патологии. В заушной области слева пальпируется плотное опухолевидное образование округлой формы, безболезненное, кожные покровы над ним не изменены, подвижны (рис. 1). Рисунок 1. Остеома левого сосцевидного отростка.
Отоскопия: в слуховых проходах патологического отделяемого нет, стенки их не изменены, барабанные перепонки с обеих сторон серого цвета, блестящие, с четко выраженными опознавательными знаками.
Шепотную и разговорную речь на оба уха больная воспринимает на расстоянии 6 м.
Больная консультирована нейрохирургом, невропатологом, окулистом. В неврологическом статусе патологических изменений не выявлено. Обнаружена ангиопатия сетчатки обоих глаз с венозным полнокровием. Проведена компьютерная томография височных костей. На серии томограмм получены изображения височных костей нормальной пневматизации, слева в задних отделах сосцевидного отростка крупноячеистое строение. По заднему краю левого сосцевидного отростка отмечается утолщение кости с четкими округлыми контурами, гомогенной структуры, без мягкотканного компонента, гиперинтенсивной плотности до +1600 ед.Н. Наружный и внутренний слуховые проходы с обеих сторон не деформированы, нормальных размеров, с четкими контурами, патологических включений в области внутреннего уха не выявлено.

Заключение: КТ-признаки остеомы сосцевидного отростка левой височной кости (рис. 2). Рисунок 2. КТ остеомы сосцевидного отростка височной кости.
Клинический диагноз: остеома сосцевидного отростка левой височной кости. После получения согласия больной на хирургическую операцию под общим обезболиванием под интубационным наркозом проведено удаление костной опухоли. Выделение остеомы из окружающих костных тканей проводили с помощью фрезы и распатора. Опухоль располагалась близко к сигмовидному синусу, однако нарушения его целостности удалось избежать.
После удаления остеомы единым блоком операционная рана была промыта раствором мирамистина и послойно ушита.

Удаленная костная опухоль имела значительные размеры - 4,5×4,5 см, массу - 32 г (рис. 3). Рисунок 3. Удаленная костная опухоль.
Результаты гистологического исследования: компактная остеома, образованная сплошной костной массой волокнистого строения с узкими сосудистыми каналами.
Через 9 дней в удовлетворительном состоянии больная выписана из отделения.
Особенностью приведенного наблюдения является редкость локализации остеомы в области сосцевидного отростка височной кости и большие размеры, что не помешало ее удалению единым блоком.
Пирамида височной кости. Топография височной кости
Пирамида височной кости. Топография височной кости
Передняя поверхность пирамиды вместе с большим крылом основной кости образует дно средней черепной ямки.
Медиально в состав последней входит верхнебоковая поверхность основной кости с турецким седлом, как бы разделяющим обе средние черепные ямки. Кнаружи стенка средней черепной ямки образована чешуей височной кости. Задняя поверхность пирамиды височной кости образует вместе с внутренней поверхностью затылочной ко стн и блюменбаховым скатом (впереди) заднюю черепную ямку.
Границей между средней и задней черепными ямками с каждой стороны являет ся верхняя грань пирамиды, несущая верхний каменистый синус.
На передней поверхности пирамиды, идя сзади наперед, следует отметить следующие образования:
1) перпендикулярно к верхней грани пирамиды, на середине ее протяжения, выпячивается eminentia arcuata, соответствующая дуге верхнего полу кружного канала;
2) кпереди кость образует крышу барабанной полости (tegmen tympani);
3) медиальное располагается щелевидный hiatus canalis facialis так называемое ложное отверстие канала лицевого нерва, ведущее к колену лицевого нерва с его gangl. geniculi;

4) от этой щели тянется бороздка для лицевого нерва к внутреннему отверстию сонного канала, лежащему кнутри, вблизи верхушки пирамиды, и образующему вместе с основной костью рваное отверстие (foramen lacerum);
5) кнаружи от внутреннего отверстия сонпого канала находится продолговатое отверстие canalis musculo-tubarius;
6) между отверстием сонного канала и верхней гранью пирамиды на верхушке пирамиды имеется неглубокая ямка — impressio trigemini (в cavum Meckelii), где находится гассеров узел тройничного нерва.
Верхушка пирамиды соединяется с задним клиновидным отростком основной кости посредством окостеневшей связки ligi. petro-sphenoidale Gruber). Под этой связкой находится канал Дорелло, через который проходят нижняя каменистая пазуха и отводящий нерв.
При гнойном воспалении верхушки пирамиды или отеке в области канала Дорелло может возникнуть парез или паралич отводящего нерва, а также произойти раздражение гассерова узла.
На задней поверхности пирамиды височной кости расположено отверстие внутреннего слухового прохода (meatus acusticus internus), через которое проходят слуховой, лицевой и промежуточный (п. intermedins) нервы, слуховые артерия и вена. Кнаружи и выше отверстия имеется fossa subarcuata, куда входит отросток твердой мозговой оболочки.

Кзади и ниже этой ямки имеется щелевидпое отверстие — apertura externa aquaeductus vestibuli, ведущее в канал, где проходит ductus endolymphaticus, слепо заканчивающийся saccus endolymphaticus, располагающимся непосредственно под ще-левидным отверстием.
Твердая мозговая оболочка плотно соединена с височной костью и заключает в себе венозные пазухи, собирающие кровь из мозга и костей черепа. Стенки этих пазух образованы самой твердой мозговой оболочкой, и вследствие плотности последней просвет пазухи не спадается даже при повышенном внутричерепном давлении.
Непосредственное отношение к височной кости, особенно к полостям среднего уха, имеет поперечная пазуха (sinus transvcrsus), которая начинается в conf luens sinuum или torcular Herophili. Она располагается в одноименной борозде на внутренней поверхности затылочной кости, переходит на внутреннюю поверхность сосцевидного отростка (здесь она называется сигмовидной пазухой), затем поворачивает вниз почти под прямым углом, переходя в луковицу внутренней яремной вены.
Поперечпая пазуха обычно постоянна в своей топографии, но иногда она слабо развита. Топография сигмовидной пазухи подвержена довольно частым и клинически важным вариантам в зависимости от глубины внедрения последней (пазухи) в сосцевидный отросток.
Вопрос 13 Височная кость: ее части, отверстия и их значение
Височная кость, os temporale, парная кость, имеет сложное строение, так как выполняет все 3 функции скелета и не только образует часть боковой стенки и основания черепа, но и содержит в себе органы слуха и гравитации. Она является продуктом слияния Нескольких костей (смешанная кость), самостоятельно существующих y некоторых животных, и потому состоит из Трех частей: 1) чешуйчатая часть, pars squamosa;
2)барабанная часть, pars tympanica
3) каменистая часть, pars petrosa.
B течение 1-го года жизни они сливаются в единую кость, замыкая наружный слуховой проход, meatus acusticus externus, таким образом, что чешуйчатая часть лежит над ним, каменистая часть кнутри от него, a барабанная сзади, снизу и спереди. Следы слияния отдельных частей височной кости сохраняются на всю жизнь в виде промежуточных швов и щелей,a именно: на границе pars squamosa и pars petrosa, на передневерхней поверхности последней — fissura petrosquamosa; в глубине нижнечелюстной ямки —fissura tympanosquamosa, которая разделяется отростком каменистой части на fissura petrosquamosa и fissura petrotympanica (через нее выходит нерв chorda tympani).
Чешуйчатая часть, pars squamosa, участвует в образовании боковых стенок черепа. Она относится к покровным костям, т. e. окостеневает на почве соединительной ткани и имеет сравнительно простое строение в видевертикально стоящей пластинки c закругленным краем, накладывающимся на соответственный край теменной кости,margo squamosa, в виде чешуи рыб, откуда и произошло ее название.
На мозговой поверхности ее, facies cerebralis, заметны следы мозга, пальцевые вдавления, impressiones digitatae, и восходящая кверху бороздка от a. meningea media. Наружная поверхность чешуи гладкая, участвует в образовании височной ямки и поэтому называется facies temporalis. От нее отходитскуловой отросток, processus zygomaticus, который идет вперед на соединение со скуловой костью. У своего начала скуловой отросток имеет два корня: передний и задний, между которыми находится ямка для сочленения c нижней челюстью,fossa mandibularis. На нижней поверхности переднего корня помещается суставной бугорок, tuberculum articulare,препятствующий вывиху головки нижней челюсти вперед при значительном открывании рта.
Барабанная часть, pars tympanica, височной кости образует передний, нижний и часть заднего края наружного слухового прохода, окостеневает эндесмально и, как все покровные кости, имеет вид пластинки, только резко изогнутой.
Наружный слуховой проход, meatus acusticus externus,представляет собой короткий канал, направляющийся внутрь и несколько вперед и ведущий в барабанную полость. Верхний край его наружного отверстия, porus acusticus externus, и часть заднего края образуются чешуей височной кости, а на остальном протяжении - барабaнной частью.
У новорожденного наружный слуховой проход еще не сформирован, так как барабанная часть представляет неполное кольцо (annulus tympanicus), затянутое барабанной перепонкой. Вследствие такого близкого расположения барабанной перепонки кнаружи у новорожденных и детей раннего возраста более часто наблюдаются заболевания барабанной полости.

Каменистая часть, рагs petrosa, названа так по прочности своего костного вещества, обусловленной тем, что эта часть кости участвует в основании черепа, и является костным вместилищем органов слуха и гравитации, имеющих весьма тонкое строение и нуждающихся в прочной защите от повреждений. Развивается она на основе хряща. Второе название этой части - пирамида, дано по ее форме тpехгранной пирaмиды, основание которой обращено кнаружи, a верхушка — впереди внутрь к клиновидной кости.

Пирамида имеет три поверхности : переднюю, заднюю и нижнюю.Передняя поверхность входит в состав дна средней черепной ямки; задняя поверхность обращена назад и медиально и образует часть передней стенки задней черепной ямки; нижняя поверхность обращена вниз и видна только на наружной поверхности основания черепа. Внешний рельеф пирамиды сложен и обусловлен строением ее как вместилища для среднего (барабанная полость) и внутреннего уха (костный лабиринт, состоящий из улитки и полукружных каналов), а также прохождением нервов и сосудов. На передней поверхностипирамиды, близ ее верхушки, заметно небольшое вдавление,impressio trigemini, от узла тройничного нерва (n. trigemini,).Кнаружи от него проходят две тонкие бороздки, медиальная -sulcus n. petrosi majoris, и латеральная - sulcus n. petrosi minoris.Они ведут к двум соименным отверстиям: медиальному, hiatus canalis n. petrosi majoris, и латеральному, hiatus canalis n. petrosi minoris. Кнаружи от этих отверстий заметно дугообразноевозеышениe, eminentia arcuata, образующееся благодаря выпячиванию бурно развивающегося лабиринта, в частности верхнего полукружного канала. Поверхность кости междуeminentia arcuata и squama temporalis образует крышу барабанной полости, tegmen tympani.
Приблизительно на середине задней поверхностипирамиды находится внутреннее слуховое отверстие, porus acusticus internus, которое ведет во внутренний слуховой проход, meatus acusticus internus, где проходят лицевой и слуховой нервы, a также артерия и вены лабиринта.
От нижней поверхности пирамиды; обращенной на основание черепа, отходит тонкий заостренный шиловидный отросток, processus styloideus, служащий местом прикрепления мышц «анатомического букета» (mm. styloglossus, stylohyoideus, stylopharyngeus), a также связок — ligg. stylohyоideus и stylomandibulare. Шиловидный отросток представляет часть височной кости жаберного происхождения. Вместе c lig. stylohyoideum он является остатком подъязычной дуги.
Между шиловидным и сосцевидным отростками находитсяшилососцевидное отверстие, foramen stylomastoideum,через которое выходит n. facialis и входит небольшая артерия. Медиально от шиловидного отростка расположена глубокаяяремная ямкa, fossa jugularis. Кпереди от fossa jugularis,отделенное от нее остpым гребнем, находится наружноеотверстие сонного канала, foramen caroticum externum.
Пирамида имеет три края : передний, задний и верхний. Короткий передний край образует остpый угол c чешуей. B этом углу заметно отверстие мышечнотрубного канала, canalis musculotubarius, ведущего в барабанную полость. Канал этот перегородкой делится на два отдела: верхний и нижний. Верхний, меньший, полуканал, semicanalis m. tensoris tympani, вмещает в себя этот мускул, a нижний, больший, semicanalis tubae auditivae, представляет собой костную часть слуховой тpубы, служащей для проведения воздуха из глотки в барабанную полость. По верхнему краю пирамиды, разделяющему переднюю и заднюю поверхности, проходит хорошо заметная бороздка, sŭlcus sinus petrosi superidris, — след одноименного венозного синуса.
Задний край пирамиды кпереди от fossa jugularisсоединяется c базилярной частью затылочной кости и образует вместе c этой костью sulcus sinus petrosi inferioris — след нижнего каменистого венозного синуса.
Наружная поверхность основания пирамиды служит местом прикрепления мышц, чем и обусловлен ее наружный рельеф (отросток, вырезки, шероховатости). Книзу она вытягивается всосцевидный отросток, processus mastoideus. K нему прикрепляется грудино-ключично-сосцевидная мышца, которая поддерживает голову в равновесии, необходимом при вертикальном положении тела. Поэтому сосцевидный отросток отсутствует y четвероногих и даже человекоообразных обезьян и развивается только y человека в связи c его прямохождением. На медиальной стороне сосцевидного отростка имеется глубокая сосцевидная вырезкa, incisura mastoidea, — место прикрепления m. digastricus; еще более кнутри — небольшаяборозда, sulcus a. occipitalis, — след одноименной артерии.
На наружной поверхности основания сосцевидного отростка выделяют гладкий треугольник, который является местом для оперативного доступа к ячейкам сосцевидного отростка при заполнении их гноем.
Внутри сосцевидный отросток и содержит эти ячейки,cellulae mastoideae, которые представляют собой отделенные костными перекладинами воздушные полости, получающие воздух из барабанной полости, c которой они сообщаются через посредство antrum mastoideum. На мозговой поверхности основания пирамиды проходит глубокая борозда, sulcus sinus sigmoidei, где лежит одноименный венозный синус.

Каналы височной кости. Самым крупным каналом является сонный канал, canalis caroticus, через который проходит внутренняя сонная артерия. Начавшись своимнаружным отверстием на нижней поверхности пирамиды, он поднимается кверху, затем изгибается под прямым углом и открывается своим внутренним отверстием y верхушки пирамиды медиально от canalis musculotubarius. Лицевой канал, canalis facialis, начинается в глубине porus acusticus internus, откуда канал сначала идет впереди латерально до щелей (hiatus) на передней поверхности пирамиды; у этих отверстий канал, оставаясьгоризонтальным, поворачивает под прямым углом латерально и назад, образуя изгиб - коленце,geniculum canalis facialis, a затем вниз и заканчивается посредством foramen stylomastoideum, расположенным на нижней поверхности пирамиды височной кости. Canalis musculotubarius (см. выше).
Варианты и аномалии
Яремная вырезка височной кости может быть разделена межъяремным отростком на две части. Если имеется такой же отросток в яремной вырезке затылочной кости, образуется двойное яремное отверстие. Шиловидный отросток височной кости может отсутствовать, но чаще бывает длинным, даже может достигать подъязычной кости в случае окостенения шило-подъязычной связки.
КАНАЛЫ ВИСОЧНОЙ КОСТИ или как понять одну из неЛЮБИМЫХ тем студентов-медиков👀
Лабиринты бывают не только в жизни, но и в нашей голове, точнее черепе, височная кость регулярно об этом напоминает каждому медику на 1 курсе.
В височной кости 7 каналов:
1) Сонный канал (canalis caroticus)
2) Канал лицевого нерва (canalis nervi facialis)
3) Мышечно-трубный канал (canalis musculotubarius)
4) Мышечно-трубный канал (canalis musculotubarius)
5) Барабанный каналец (canaliculus tympanicus)
6) Сосцевидный каналец (canaliculus mastoideus)
7) Самые маленькие – сонно-барабанные канальцы (canaliculi cаroticotympanici)
Теперь о каждом канале поподробнее😉
СОННЫЙ КАНАЛ canalis caroticus
Начало – наружное отверстие сонного канала на нижней поверхности пирамиды.
Конец – внутреннее отверстие сонного канала на верхушке пирамиды.
Содержимое канала : внутренняя СОННАЯ артерия
Ход канала : начинается на нижней поверхности пирамиды, дальше он в толще пирамиды делает поворот под прямым углом и направляется к верхушке пирамиды, где собственно и заканчивается его путь.
КАНАЛ ЛИЦЕВОГО НЕРВА canalis nervi facialis
Начало – на дне внутреннего слухового прохода.
Конец – шилососцевидное отверстие на нижней поверхности пирамиды
Содержимое канала: ЛИЦЕВОЙ нерв
Ход канала: начало на дне слухового прохода, дальше направляется перпендикулярно оси пирамиды, у расщелины канала большого каменистого нерва он делает поворот назад и латерально под прямым углом в горизонтальной плоскости, этот поворот называется коленцем канала лицевого нерва ( geniculum canalis nervi facialis ), у задней стенки барабанной полости канал снова делает поворот попадая из горизонтальной плоскости в вертикальную и заканчивается на нижней поверхности пирамиды височной кости шилососцевидным отверстием.
Самые важные каналы мы рассмотрели, теперь перейдем к остальным, как правило, от них требуют 3 вещи – начало, конец и содержимое. Приступим!
МЫШЕЧНО-ТРУБНЫЙ КАНАЛ canalis musculotubarius
Данный канал состоит из двух полуканалов:
1) полуканал мышцы, напрягающей барабанную перепонку ( semicanalis musculi tensor timpani )
2) полуканал слуховой трубы ( semicanalis tubae auditivae )
Начало – отверстие мышечно-трубного канала на переднем крае пирамиды.
Конец - в барабанной полости.
Содержимое: мышца, напрягающая барабанную перепонку и слуховая труба.
КАНАЛЕЦ БАРАБАННОЙ СТРУНЫ canaliculus chordate tympani
Начало – в лицевом канале, выше шилососцевидного отверстия (т.е. рядом с концом канала лицевого нерва).
Конец – каменисто-барабанная щель.
Содержимое: барабанная струна (ветвь лицевого нерва).
БАРАБАННЫЙ КАНАЛЕЦ canaliculus tympanicus
Начало – каменистая ямочка на нижней поверхности пирамиды (рядом с местом начала сонного канала).
Конец – расщелина канала малого каменистого нерва на передней поверхности пирамиды.
Содержимое: барабанный нерв (ветвь языкоглоточного нерва).
СОСЦЕВИДНЫЙ КАНАЛЕЦ canaliculus mastoideus
Начало – яремная ямка на нижней поверхности пирамиды.
Конец – барабанно-сосцевидная щель.
Содержимое: ушная ветвь блуждающего нерва.
СОННО-БАРАБАННЫЕ КАНАЛЬЦЫ canaliculi coroticotympanici
Начало – на стенке сонного канала, возле его наружной апертуры.
Конец – барабанная полость (т.е. в барабанной полости заканчиваются эти канальцы + мышечно-трубный канал).
Содержимое – сонно-барабанные артерии (от внутренней сонной артерии) и сонно-барабанные нервы (от внутреннего сонного сплетения).
Ну а теперь самое важное, как все запомнить?! Предлагаю новую привычку – мантру утром и вечером, а потом можно перейти и на йогу🌸
Понравилась статья? Поделись ей в социальных сетях!
Статьи других преподавателей
Курсы по патологической анатомии
Время чтения 2 минуты

Курсы по патологической физиологии
Время чтения 2 минуты

Курсы по нормальной физиологии
Время чтения 2 минуты

Курсы по медицинской биологии
Время чтения 2 минуты

Курсы по фармакологии
Время чтения 3 минуты
Проект, где студенты медицинских университетов могут перенять опыт старших товарищей и иметь доступ к качественной информации.
Каналы височной кости. Анатомия: височная кость
Каждая кость человеческого организма является важнейшим "винтиком" в огромном механизме. Головные костные элементы выполняют защитную функцию. К таким элементам относится височная кость.
Височная кость: описание
Немаловажную часть черепной коробки составляет височная кость, которая располагается с двух сторон черепа, а следовательно, является парной. Если сказать точнее, то она принадлежит к одной из составляющих черепа, покрывающих головной мозг. Окружают ее клиновидная, теменная и затылочная кости.

Этот костный элемент в комплексе с нижней челюстью образует подвижный сустав. А в тандеме со скуловой костью они составляют скуловую дугу.
Сам височный элемент являет собой нецельную кость: он представлен рядом частей, которые его образуют.

К периоду, предшествующему рождению, височная кость уже состоит из чешуйчатой части, барабанной и каменистой части, а в промежутке этих частей расположены расщелины с соединительной тканью.
Строение кости
Анатомия височной кости выглядит следующим образом. В ней выделяют пирамиду, барабанную часть и чешую.
Пирамиду еще называют каменистой частью. И неспроста, ведь этот элемент состоит из очень твердого костного элемента. По своей форме каменистая часть очень похожа на трехгранную пирамиду (отсюда и название). Основание пирамиды выводится в сосцевидный отросток.
Состоит пирамида из следующих частей: верхушка; фронтальная, задняя и нижняя поверхности; апикальный, задний и нижний край.
Фронтальная поверхность пирамиды обладает направленностью, выраженной вперед и вверх. С боковой стороны пирамида переходит в чешую височной кости. Между этими двумя элементами височной кости располагается каменисто-чешуйчатое отверстие. В своей центральной части передняя поверхность пирамиды имет небольшое дугообразное возвышение. На расстоянии через эти возвышения в виде чешуйчатого отверстия расположен плоский участок, который выполняет функцию крыши барабанной полости.
Задняя поверхность пирамиды прилегает к центру. Практически в центральной части этой поверхности пирамиды есть небольшое слуховое отверстие, которое перетекает во внутренний слуховой канал. С боковой стороны слухового отверстия расположена поддужная ямка. А по нижней стороне имеется отверстие водопровода преддверия.
Нижняя поверхность пирамиды оснащена непростым поверхностным рельефом. Нижняя поверхность перетекает в сосцевидный отросток.
Верхний край пирамиды является пограничной линией, скрепляющей фронтальную и заднюю поверхности. По его основанию располагается борозда каменистого синуса.
Задний край пирамиды разграничивает заднюю и нижнюю поверхности. Вдоль его поверхности лежит бороздка нижнего каменистого синуса. Около боковой стороны борозды находится ямочка с внешним отверстием канальца улитки.
С внутренней стороны пирамида размещает органы слуха и балансировки.

На схеме изображено:

- Чешуйчатая часть или чешуя. Этот костный элемент имеет выгнутую снаружи форму пластины, верхний край которой скошен. Свое название — чешуя — эта часть получила из-за того, что она накладывается соответствующим (чешуйчатым) образом на соседний конец теменной кости и крыло клиновидной кости. С нижнего края она смыкается с пирамидой сосцевидными отростками и барабанной частью. Внешняя сторона, имеющая гладкую структуру, образует височную ямку. От чешуи берет свое начало скуловой отросток, направляющийся в сторону височного отростка скуловой кости и прикрепляется с ним своим зазубренным краем, образуя скуловую дугу. Ниже изображены чешуйчатые края.
- Скуловой отросток. Этот элемент служит соединительной частью со скуловой костью. В основании отростка лежат два его корня: фронтальный и задний, а между ними размещена ямка, предназначенная для крепления с нижней челюстью.
- Суставной бугорок. Он расположен на нижнем крае фронтального корня скулового отростка. Его функция весьма значима для челюстного отдела — недопущение смещения головки нижней челюстной кости вперед в момент широкого раскрытия рта.
- Нижнечелюстная ямка. Она обособлена от внешнего слухового прохода тонкой пластинкой, выполненной из костного вещества. Такое разграничение хорошо влияет на процесс перемещения патологического процесса с ушной раковины на суставную часть и в обратном направлении.
- Наружное слуховое углубление. Это отверстие расположенно с боковой внешней стороны височной кости. Оно покрыто сверху чешуей, с тыльной сосцевидной, с фронтальной и нижней – барабанной частью височной кости.
- Глазерова щель, иначе называется каменисто-барабанной. Это узкая полость, разграничивающая барабанную часть, участок височной кости и выступающий край крыши барабанной полости;
- Барабанная часть. Это костная пластина, не крупная по размеру и изогнутая по форме. Она прикрепляется к соседним участкам височной кости. Барабанная часть защищает внешнее слуховое отверстие, обволакивая его с трех сторон в совокупности с чешуей и сосцевидным отростком. Эти три участка височной кости срастаются с переднего конца, сзади и снизу. Место их срастания называется сосцевидно-барабанной щелью, она расположенна позади слухового отверстия. Слуховое отверстие переходит в слуховой проход, конечной точкой которого является барабанная полость. С фронтальной части разъема пролегает барабанно-чешуйчатая расщелина.
- Сосцевидный отросток. Это задний фрагмент височной кости, который располагается позади слухового отверстия. От чешуйчатой части он отграничен теменной вырезкой. С внешней стороны к сосцевидному отростку крепятся мышцы головы, они хорошо удерживаются благодаря его выпуклой и шершавой поверхности.
- Шиловидный отросток. Он представлен участком соединения мышечных тканей и связок. Шиловидный отросток – это фрагмент височной кости, который по характеру своего формирования имеет жаберную природу. Он является остаточным элементом подъязычной дуги.
Функции

Височная кость выполняет три функции:
- Защитная. Височная кость в совокупности с остальными костями черепа предохраняет головной мозг от разного рода повреждений.
- Опорная. Черепная кость височной доли поддерживает головной мозг, являясь его опорой.
- Височная кость – место крепления головных мышц.
Кроме того, эта кость содержит органы и каналы слухового аппарата, равновесия, а также в ней пролегают различные канальцы и сосуды.
Выполняемые функции полностью зависят от анатомии височной кости. Кроме того, расположение близлежащих костей также влияет на функциональность.
Каналы височной кости
Височная кость полностью исчерчена различными выемками, впадинами и канальцами. Каналы и полости височной кости служат для проведения сосудов, нервных ветвей, артерий. Каналы представляют из себя полые трубчатые тяжи, переплетающие части височной кости.
Ниже представлена таблица каналов височной кости.
Канал лицевого нерва

Рассмотрим лицевой канал височной кости. Он берет начало на нижней стороне слухового аппарата, расположенного внутри уха. Его направленность выражена латерально – вперед к расщелине канала каменистого нервного волокна. На этом участке он образует виток, который называется коленцем лицевого канала. Продолжает свой путь лицевой канал височной кости от коленца в направлении сбоку и назад, по траектории прямого угла параллельно оси пирамиды. Затем направление становится вертикальным и заканчивается сосцевидным отверстием у тыловой стенки барабанной полости.
Сонный канал
Сонный канал височной кости начинает свой путь на нижней стороне пирамиды в виде отверстия (апертуры). Его направленность — прямо и вверх, но уже ближе к поверхности пирамиды. Канал совершает изгиб под углом 90 и выходит внешним отверстием на апексе пирамиды. Через канал проходит сонная артерия.
Мышечно-трубный канал
Мышечно-трубный канал височной кости — это фрагмент слуховой трубы аппарата внутреннего уха. Начинается канал в верхушке пирамиды, а именно: располагаясь между ее фронтальным краем и чешуей височной кости.
Каналец барабанной струны
Этот каналец начинается от канала лицевого нерва, но его начало расположено несколько выше от шилососцевидного отверстия, а завершается в каменисто-барабанной щели. Содержимое этого канала височной кости в таблице было рассмотрено более подробно.
Сосцевидный каналец
Свое начало каналец берет в яремной ямке, пересекает нижний отдел лицевого канала и заканчивается в сосцевидно-барабанной щели. Сосцевидный канал через свою полость проводит отросток блуждающего нерва.
Барабанный каналец
Барабанный каналец берет свое начало со дна каменистой ямочки. Свой путь продолжает в направлении вверх и прямо. Пересекает расположенный снизу участок барабанной полости и устремляется наверх мыса, но уже в виде бороздки. Его конец выходит сквозь расщелину каменистого нерва, расположенного на передней стороне пирамиды височной кости.
Барабанный канал содержит в своей полости барабанный нерв.
Сонно–барабанные канальцы
Всего имеется два сонно-барабанных канальца. Начинаются они от стенки сонного канала, откуда далее выводятся в барабанную полость. Функция этих каналов — проведение.

Каналы височной кости схематично отображены выше. Они показывают комплексность процессов, протекающих в кости.
Читайте также:
